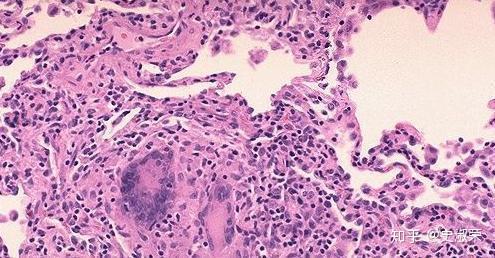
该病可由各种感染(如ebv,寄生虫)性疾病,血液疾病特别是淋巴瘤引起.

淋巴寄生虫

班氏乌chereria bancrofti,淋巴丝虫病病原体
图片尺寸1200x800
人体寄生虫饭前勿看
图片尺寸640x427
6血液与淋巴系统寄生虫.ppt
图片尺寸1296x864
猪身上"最脏"的部位,有大量寄生虫,很多人贪便宜,傻傻买来当美食
图片尺寸850x469
男子颈部长虫窝取出2条活虫-寄生虫,虫子 ——快科技(驱动之家旗下
图片尺寸417x545
曼氏迭宫绦虫裂头蚴简称裂头蚴,是曼氏迭宫绦虫引发的寄生虫病,裂头蚴
图片尺寸510x539
寄生虫藏屠夫体内,数量惊人,本图为示意图.(图/达志/示意图)
图片尺寸600x450
丝虫病会主要堵到淋巴管里面去,丝虫是一种寄生虫,寄宿在人体淋巴组织
图片尺寸450x298
贵阳星力百货集团有限公司--人体10大寄生虫的真面目
图片尺寸757x550
发病过程分为四个时期和三种类型|炎症|寄生虫|淋巴管_网易订阅
图片尺寸482x511![69 人体寄生虫[7p]不喜勿入 钻入皮肤→皮下组织→侵入血管及淋巴](https://i.ecywang.com/upload/1/img1.baidu.com/it/u=3283363078,3147979091&fm=253&fmt=auto&app=138&f=JPEG?w=400&h=300)
69 人体寄生虫[7p]不喜勿入 钻入皮肤→皮下组织→侵入血管及淋巴
图片尺寸400x300
并发现,带有这种寄生虫的小白鼠会发生胃癌,还转移到了淋巴结和肺部
图片尺寸572x500
寄生虫装片
图片尺寸500x380
掠夺营养物质:寄生虫在鸽体内寄生时,常常以经口吞食或由体表吸收的
图片尺寸550x183
大马女子去port dickson玩耍时没穿鞋, 寄生虫从脚底钻进体内成噩梦!
图片尺寸634x338
"现象市民买到疑似注水,藏针,有寄生虫的猪肉罗先生发来的图片中,从
图片尺寸640x1138
该病可由各种感染(如ebv,寄生虫)性疾病,血液疾病特别是淋巴瘤引起.
图片尺寸495x258
健康,寄生虫,人体,危害
图片尺寸450x375
明明几十年前几乎人人都有|蛔虫病|寄生虫|虫卵|感染率|驱虫_网易订阅
图片尺寸640x496
检测出一种新的淋巴囊虫病毒|宿主|细菌|寄生虫|病原体|水生动物_网易
图片尺寸640x391








![69 人体寄生虫[7p]不喜勿入 钻入皮肤→皮下组织→侵入血管及淋巴](https://i.ecywang.com/upload/1/img1.baidu.com/it/u=3283363078,3147979091&fm=253&fmt=auto&app=138&f=JPEG?w=400&h=300)


















![69 人体寄生虫[7p]不喜勿入 钻入皮肤→皮下组织→侵入血管及淋巴](https://cimg2.163.com/cnews/2007/4/30/2007043008183855e1b.jpg)